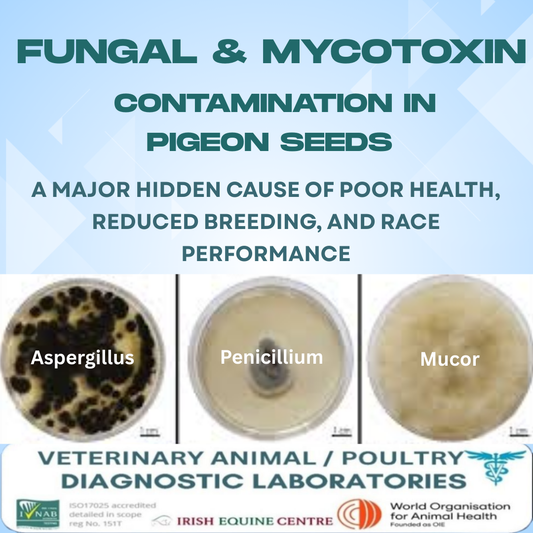
Pilz- und Mykotoxine in Taubensamen

Kategorie: Erweiterte Labortests für Tauben.
Diagnostische Laborberichte
Alle Berichte werden von unserem Leiter der Mikrobiologie , MVB PhD DipECVM , unterzeichnet , der EBVS-Europäischer Spezialist für Veterinärdiagnostik ist. Leiter der Virologie MVB, PhD, MRCVS, spezialisiert auf Vakzinologie, Diagnostik und Krankheitskontrolle. Leiter der Pathologie BSc MVB, DipECEIM, FRCPath, MRCVS RCVS-Spezialist für Veterinärpathologie.
Wir sind mit fortschrittlichen mikrobiologischen Werkzeugen ausgestattet, darunter das VITEK II-System zur Bakterienidentifizierung und Empfindlichkeitsprüfung.
-
Allgemeiner Loft-Test (erweiterter diagnostischer Labortest)
Normaler Preis £125.00Normaler PreisGrundpreis / pro -
Salmonella-Paratyphoid Typhimurium-Test von Racing Pigeon Laboratory Testing .com
Normaler Preis £95.00Normaler PreisGrundpreis / pro -
Atemwege Chronische Atemwege von Racing Pigeon Laboratory Testing.com
Normaler Preis £85.00Normaler PreisGrundpreis / pro -
Antibiotika-Empfindlichkeitstest für Brieftauben, auch bekannt als Bakterienkultur- und Empfindlichkeitstest
Normaler Preis £60.00Normaler PreisGrundpreis / pro -
Pilz- und Mykotoxine in Taubensamen
Normaler Preis £50.00Normaler PreisGrundpreis / pro -
PCR-Taubentest auf virale Erreger. Virus
Normaler Preis £150.00Normaler PreisGrundpreis / pro -
Laboruntersuchungen bei Pferden
Normaler Preis £0.00Normaler PreisGrundpreis / pro -
Begleit- und Tierversuche
Normaler Preis £0.00Normaler PreisGrundpreis / pro